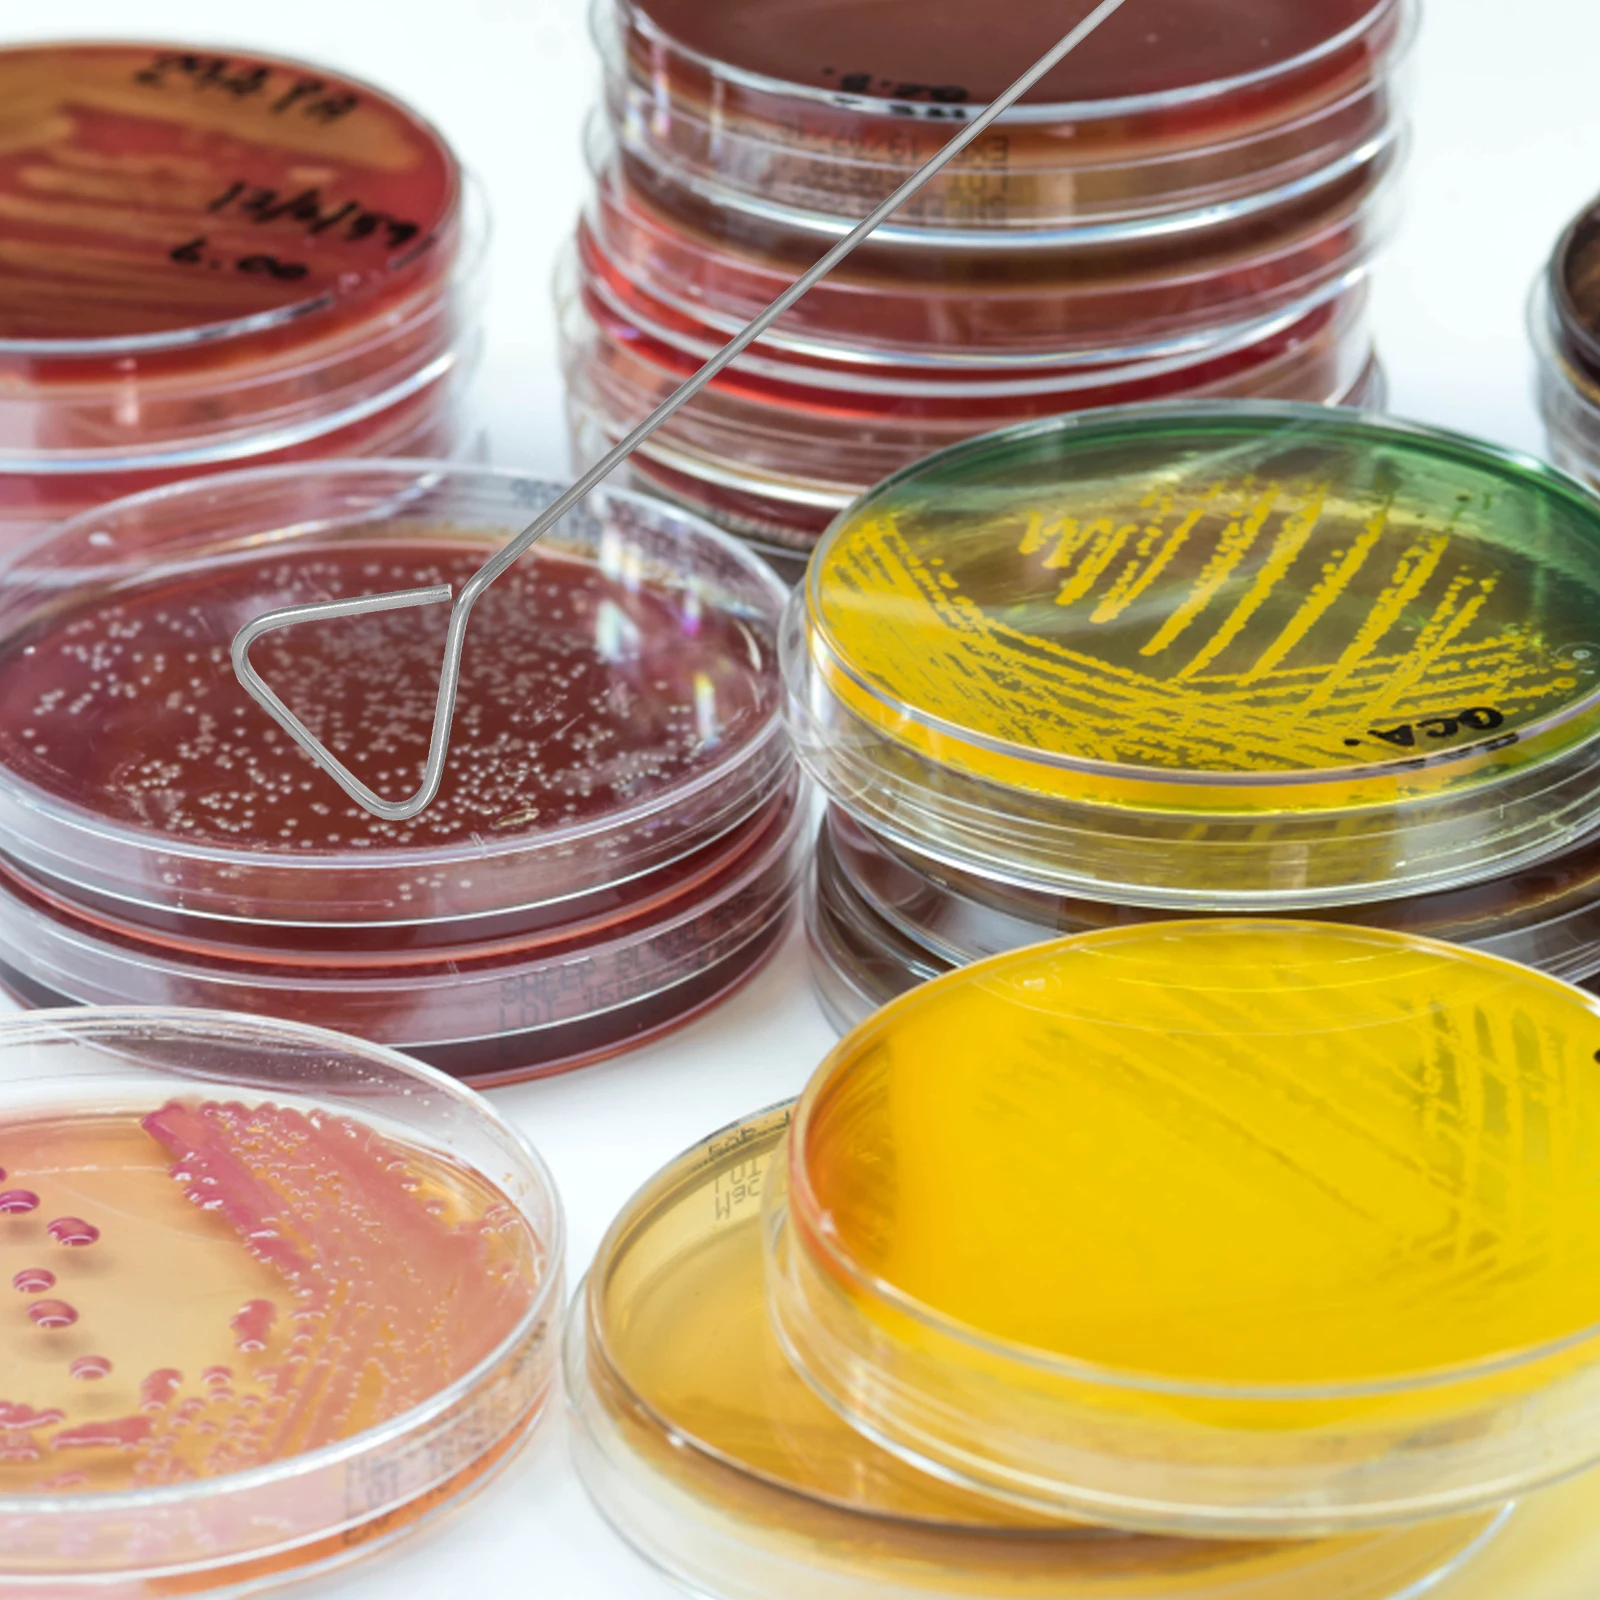

Набір металевих приманок для риболовлі з 10 предметів. Набір золото-срібних приманок із блискітками onesize
Price history chart & currency exchange rate
Customers also viewed

2,033.87 грн.
44 см Android 18 Драконий жемчуг Z Gk лазури Аниме фигурки Сексуальная Статуэтка Модель Куклы комната украшения коллекционные игрушки подарки
aliexpress.ru
1,177.11 грн.
Ручная лебедка 600-3000 фунтов, ручная лебедка, трос, тяга, подъемная лебедка, полная спецификация, лебедки, пищащие
aliexpress.com
479.07 грн.
Kanye West High Quality print Hoodie Men Women vintage hip hop streetwear Fleece Long sleeve hoodies Unisex pullover Sweatshirts
aliexpress.com
897.48 грн.
Crossfox лампы CSP лампы для автомобильных фар 6000K высокая 9005 низкая H11 с системой отвода тепла для Chevrolet Колорадо 2015 2016-2019
aliexpress.com
397.22 грн.
Metal Tin Sign Beware! Guard Crocodile On Duty Quote Wall Art Metal Sign 12x8 Inches
aliexpress.com
297.08 грн.
Grip Power Wrist Forearm Hand Grip Arm Trainer Adjustable Forearm Hand Wrist Exercises Force Trainer Power Strengthener Grip
aliexpress.com
163.71 грн.
Boty Panske женские сандалии детские женские летние тапочки Zapatiilas Женская ортопедическая обувь сандалии для телесного тенниса
aliexpress.com
229.36 грн.
BROSHOO Car Rear Wiper Blades Back Windscreen Wiper Arm For MG GS Hatchback (2013 Onwards) 345mm,Auto Accessories Styling
aliexpress.com
84.35 грн.
Wholesale 9 in 1 Mobile Phone Repair Tools Kit Spudger Pry Opening Tool LCD Repair Tools Sucker for repairing phone
aliexpress.com
37,395.00 грн.
Итальянская Минималистичная прикроватная тумбочка в скандинавском стиле, современная бытовая версия, маленький семейный шкаф
aliexpress.ru
1,557.29 грн.
Женский костюм для джазовых танцев, бюстгальтер со стразами, брюки с высокой талией для танцев на Пилоне, сексуальный наряд для ночного клуба, певицы, одежда в стиле "диджей", 2438
aliexpress.ru
1,116.86 грн.
Солнцезащитный легкий плащ-бомбер мужская летняя Тонкая Повседневная одежда 2022 новая ветрозащитная куртка Varsity
aliexpress.ru
4,071.90 грн.
340mm Motorcycle rear shock absorber for Yamaha Honda Kawasaki Suzuki ATV bm150 BAJA
aliexpress.com
3,589.92 грн.
2016 Carnival Brand Watch Fashion Automatic Mechanical Watch Tourbillon Men Watch Luminous Waterproof Steel Watches 660G-LB14
aliexpress.com
350.27 грн.
22cm * 32cm high quality pelt genuine rabbit fur raw material clothing accessories wholesale original rabbit real leather fur
aliexpress.com
46.54 грн.
Trash Bag Holder Storage Rack Organizer Garbage Hanging Cupboard Simple Waste Bag Towel Holding Kitchen Square Dropshpping
aliexpress.com51.04 грн.
(ISI 50 PCS) STICKER LABEL BUKU PELAJARAN SEKOLAH BISA CUSTOM NAMA DAN FOTO MOTIF NARUTO
shopee.co.id
130.38 грн.
alloy car model, race car, formula one, suv,sports car, multicolor,boy' toy,high simulation,kid' christmas gifts,collecting,home d
dhgate.com
2,819.01 грн.
mercurial superfly vii 7 360 elite se fg mds 002 новейшие cr7 роналдо неймар mens njr мальчиков футбол обувь бутсы бутсы сша 6.5-11
dhgate.com
335.60 грн.
Гель лак для ногтей ONIQ, Тон almond blossom, Гель-лак для покрытия ногтей PANTONE 10 мл
beloris.ru
290.43 грн.
6pcs Stainless Steel Triangle Spreader Tools Petri Dish Spreaders Laboratory Accessories Precision Coating Rod For Cell
aliexpress.ru
86.42 грн.
Diffuser Flash Diffusers Camera Lamp Softbox for Light Universal Accessories Photography
aliexpress.ru
120.08 грн.
Stainless Steel Adjustable Shower Curtain Rod Extendable Heavy Duty Home Accessory Bathroom Tension Bar No Drill Wear-Resistant
aliexpress.ru
14,778.92 грн.
55л 12 В автомобильный холодильник портативный компрессор охлаждающая морозильная камера кемпинг автомобиль домашний уличный охладитель холодильник
aliexpress.ru
306.64 грн.
Винтажный стиль мини -эмалевой бассейн для кукольных аксессуаров кухонная раковина игрушка с безопасным пластиком C90B
aliexpress.ru
3,018.61 грн.
Portable 220v Manual Heavy Business Card Cutting Machine PVC Card Right-Angle Round Corner Cutting Punch Card Cutting Machi
aliexpress.ru
493.61 грн.
Золотистошерстная кукла принцессы | Юбка в горошек и топ с цветочным принтом | Мягкая резиновая приятная для кожи кукла для семейных игр и ролевых игр (Ch
aliexpress.ru
495.69 грн.
Диспенсер для масла из нержавеющей стали, 1362 мл, большая емкость, бытовая кухонная бутылка для хранения уксуса, соуса, длинный носик, фильтр, тепло
aliexpress.ru